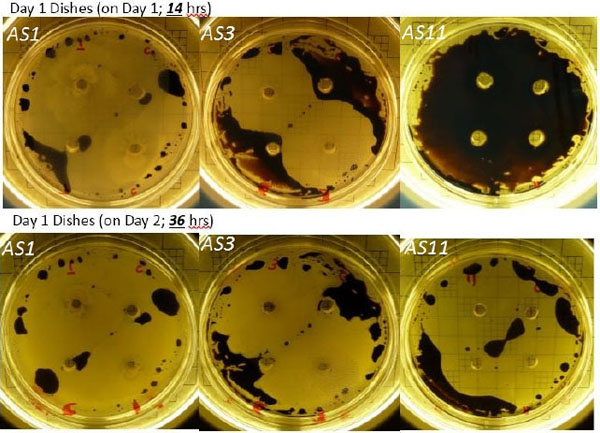

ут Ли Бактерии Фото Разлагать Воду
Могут Ли Бактерии Фото Разлагать Воду 116 фотографий
Картинки Я Люблю Тебя Любимая Оля
Антуриум Цветок Фото Сорта
Фото Едим И Худеем
Дом Фото Киров Адрес
Картинки Розы Красивые Букеты Просто Так
Снять Жилье В Анапе С Фото
Картинки Деревьев Африки
Фото Большое Головы Лошади
Кухня 5 Квадратных Метров Фото
Морковь Сорт Нииох 336 Отзывы Фото